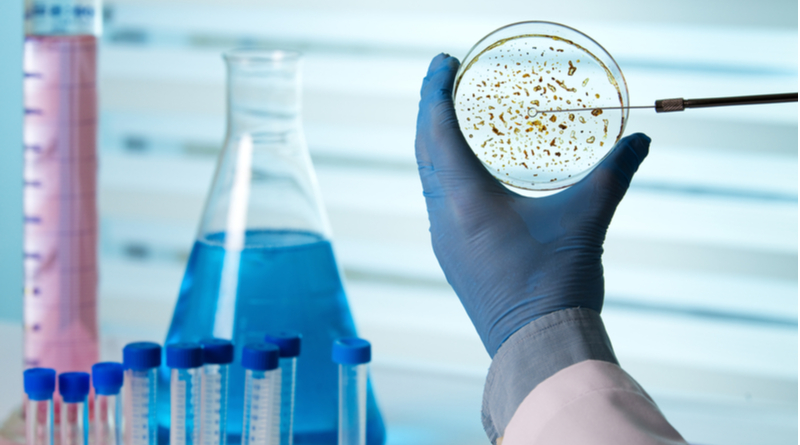

Theoretical Physics Courses
Read More
6th July 2021
Science offers a wide variety of interesting and challenging careers. If you want to do science at third-level, there are a number of choices.
You might decide on a general science degree, or you could concentrate on a particular field. These include biology and biomedical sciences, chemistry, earth sciences such as environmental science, mathematics, microbiology, nanoscience, neuroscience or physics, to name a few.